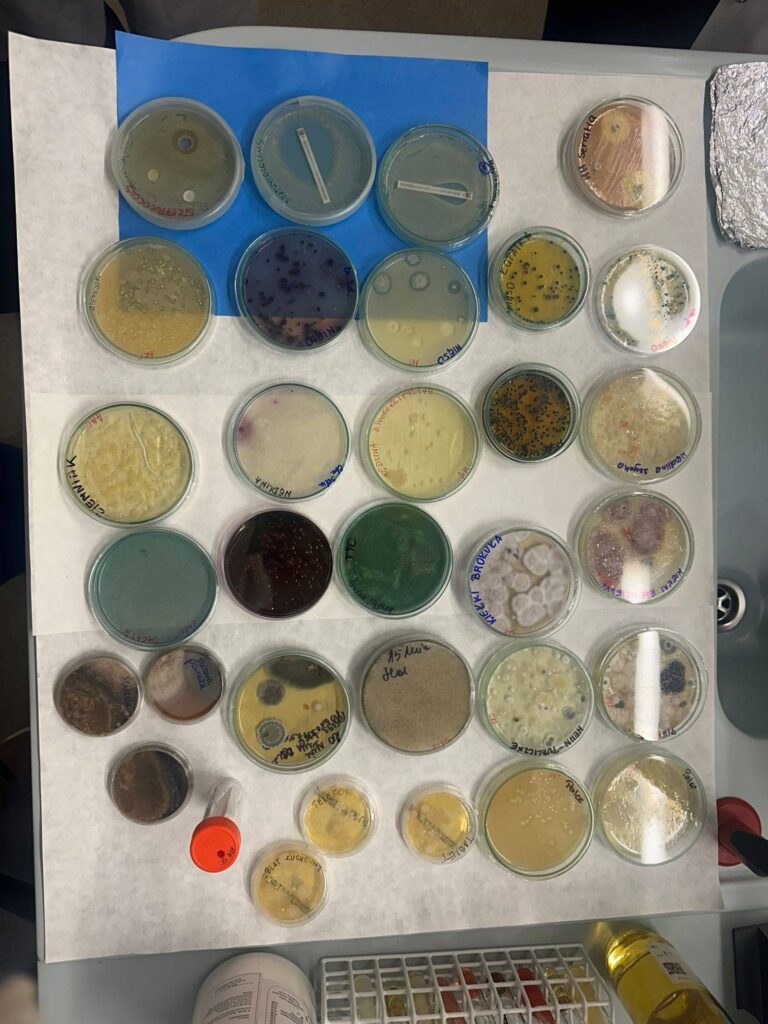

Uczniowie klasy IV i III Niepublicznego Liceum Ogólnokształcącego w Głuchołazach realizujący przedmiot biologia w zakresie rozszerzonym byli gośćmi Wydziału Przyrodniczo-Technicznego #UniwersytetOpolski podczas Dnia Otwartego 19.03.2026. Podczas wizyty w Collegium Biologicum i Collegium Biotechnologicum nasi uczniowie mieli okazję poznać zaplecze dydaktyczno-badawcze kierunków takich jak biologia, biotechnologia medyczna czy inżynierska, paleobiologia, architektura krajobrazu, ochrona środowiska i inżynieria środowiska.
W programie przewidziano pokazy w licznych pracowniach, m.in. mikrobiologii, genetyki, anatomii człowieka, ekologii, botaniki, biotechnologii, kartografii i GPS, inżynierii środowiska oraz gospodarki wodno – ściekowej, gleboznawstwa i pracowni odpadów.
To kolejne ze spotkań naszych licealistów z uczelniami wyższymi.
Dziękujemy UO za możliwość udziału w zajęciach, pozdrawiamy😍🤗